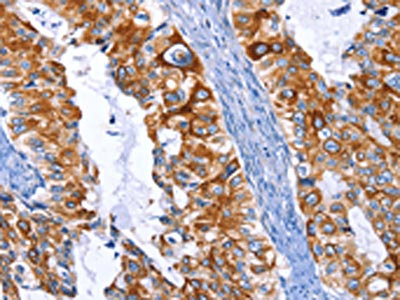

ARRB1 Antibody
-
中文名稱:ARRB1兔多克隆抗體
-
貨號:CSB-PA830451
-
規(guī)格:¥1100
-
圖片:
-
The image on the left is immunohistochemistry of paraffin-embedded Human cervical cancer tissue using CSB-PA830451(ARRB1 Antibody) at dilution 1/50, on the right is treated with fusion protein. (Original magnification: ×200)
-
The image on the left is immunohistochemistry of paraffin-embedded Human colon cancer tissue using CSB-PA830451(ARRB1 Antibody) at dilution 1/50, on the right is treated with fusion protein. (Original magnification: ×200)
-
-
其他:
產(chǎn)品詳情
-
Uniprot No.:
-
基因名:
-
別名:ARB1 antibody; ARR1 antibody; ARRB1 antibody; ARRB1_HUMAN antibody; Arrestin 2 antibody; Arrestin beta 1 antibody; Arrestin beta-1 antibody; Beta-arrestin-1 antibody
-
宿主:Rabbit
-
反應(yīng)種屬:Human,Mouse,Rat
-
免疫原:Fusion protein of Human ARRB1
-
免疫原種屬:Homo sapiens (Human)
-
標(biāo)記方式:Non-conjugated
-
抗體亞型:IgG
-
純化方式:Antigen affinity purification
-
濃度:It differs from different batches. Please contact us to confirm it.
-
保存緩沖液:-20°C, pH7.4 PBS, 0.05% NaN3, 40% Glycerol
-
產(chǎn)品提供形式:Liquid
-
應(yīng)用范圍:ELISA,IHC
-
推薦稀釋比:
Application Recommended Dilution ELISA 1:1000-1:5000 IHC 1:50-1:200 -
Protocols:
-
儲存條件:Upon receipt, store at -20°C or -80°C. Avoid repeated freeze.
-
貨期:Basically, we can dispatch the products out in 1-3 working days after receiving your orders. Delivery time maybe differs from different purchasing way or location, please kindly consult your local distributors for specific delivery time.
-
用途:For Research Use Only. Not for use in diagnostic or therapeutic procedures.
相關(guān)產(chǎn)品
靶點詳情
-
功能:Functions in regulating agonist-mediated G-protein coupled receptor (GPCR) signaling by mediating both receptor desensitization and resensitization processes. During homologous desensitization, beta-arrestins bind to the GPRK-phosphorylated receptor and sterically preclude its coupling to the cognate G-protein; the binding appears to require additional receptor determinants exposed only in the active receptor conformation. The beta-arrestins target many receptors for internalization by acting as endocytic adapters (CLASPs, clathrin-associated sorting proteins) and recruiting the GPRCs to the adapter protein 2 complex 2 (AP-2) in clathrin-coated pits (CCPs). However, the extent of beta-arrestin involvement appears to vary significantly depending on the receptor, agonist and cell type. Internalized arrestin-receptor complexes traffic to intracellular endosomes, where they remain uncoupled from G-proteins. Two different modes of arrestin-mediated internalization occur. Class A receptors, like ADRB2, OPRM1, ENDRA, D1AR and ADRA1B dissociate from beta-arrestin at or near the plasma membrane and undergo rapid recycling. Class B receptors, like AVPR2, AGTR1, NTSR1, TRHR and TACR1 internalize as a complex with arrestin and traffic with it to endosomal vesicles, presumably as desensitized receptors, for extended periods of time. Receptor resensitization then requires that receptor-bound arrestin is removed so that the receptor can be dephosphorylated and returned to the plasma membrane. Involved in internalization of P2RY4 and UTP-stimulated internalization of P2RY2. Involved in phosphorylation-dependent internalization of OPRD1 ands subsequent recycling. Involved in the degradation of cAMP by recruiting cAMP phosphodiesterases to ligand-activated receptors. Beta-arrestins function as multivalent adapter proteins that can switch the GPCR from a G-protein signaling mode that transmits short-lived signals from the plasma membrane via small molecule second messengers and ion channels to a beta-arrestin signaling mode that transmits a distinct set of signals that are initiated as the receptor internalizes and transits the intracellular compartment. Acts as signaling scaffold for MAPK pathways such as MAPK1/3 (ERK1/2). ERK1/2 activated by the beta-arrestin scaffold is largely excluded from the nucleus and confined to cytoplasmic locations such as endocytic vesicles, also called beta-arrestin signalosomes. Recruits c-Src/SRC to ADRB2 resulting in ERK activation. GPCRs for which the beta-arrestin-mediated signaling relies on both ARRB1 and ARRB2 (codependent regulation) include ADRB2, F2RL1 and PTH1R. For some GPCRs the beta-arrestin-mediated signaling relies on either ARRB1 or ARRB2 and is inhibited by the other respective beta-arrestin form (reciprocal regulation). Inhibits ERK1/2 signaling in AGTR1- and AVPR2-mediated activation (reciprocal regulation). Is required for SP-stimulated endocytosis of NK1R and recruits c-Src/SRC to internalized NK1R resulting in ERK1/2 activation, which is required for the antiapoptotic effects of SP. Is involved in proteinase-activated F2RL1-mediated ERK activity. Acts as signaling scaffold for the AKT1 pathway. Is involved in alpha-thrombin-stimulated AKT1 signaling. Is involved in IGF1-stimulated AKT1 signaling leading to increased protection from apoptosis. Involved in activation of the p38 MAPK signaling pathway and in actin bundle formation. Involved in F2RL1-mediated cytoskeletal rearrangement and chemotaxis. Involved in AGTR1-mediated stress fiber formation by acting together with GNAQ to activate RHOA. Appears to function as signaling scaffold involved in regulation of MIP-1-beta-stimulated CCR5-dependent chemotaxis. Involved in attenuation of NF-kappa-B-dependent transcription in response to GPCR or cytokine stimulation by interacting with and stabilizing CHUK. May serve as nuclear messenger for GPCRs. Involved in OPRD1-stimulated transcriptional regulation by translocating to CDKN1B and FOS promoter regions and recruiting EP300 resulting in acetylation of histone H4. Involved in regulation of LEF1 transcriptional activity via interaction with DVL1 and/or DVL2 Also involved in regulation of receptors other than GPCRs. Involved in Toll-like receptor and IL-1 receptor signaling through the interaction with TRAF6 which prevents TRAF6 autoubiquitination and oligomerization required for activation of NF-kappa-B and JUN. Binds phosphoinositides. Binds inositolhexakisphosphate (InsP6). Involved in IL8-mediated granule release in neutrophils. Required for atypical chemokine receptor ACKR2-induced RAC1-LIMK1-PAK1-dependent phosphorylation of cofilin (CFL1) and for the up-regulation of ACKR2 from endosomal compartment to cell membrane, increasing its efficiency in chemokine uptake and degradation. Involved in the internalization of the atypical chemokine receptor ACKR3. Negatively regulates the NOTCH signaling pathway by mediating the ubiquitination and degradation of NOTCH1 by ITCH. Participates in the recruitment of the ubiquitin-protein ligase to the receptor.
-
基因功能參考文獻(xiàn):
- The antitumor effect of miR296 in CRC are at least in part due to the inactivation of the RAC-alpha serine/threonine-protein kinase (AKT) signaling pathway induced by the suppression of ARRB1 expression. PMID: 30365090
- Beta-arrestin interacting with unphosphorylated ADRB2 fails to activate mitogen-activated protein kinase (MAPK) signaling and prolonged interaction of beta-arrestin with ADRB2 promoted the sorting of ADRB2 to lysosomes. PMID: 29330504
- Beta-arrestin-1 expression is associated with a poor prognosis in serous ovarian cancer patients.Beta-arrestin-1 role in the invadopodian function. PMID: 29439204
- Conformation of ADRB2 induced by the phosphorylation resulted in beta-arrestin binding. PMID: 29335412
- Bulky Phe substitution of Cys-147 in human arrestin-1 likely causes rod degeneration due to reduced stability of the protein, which induces unfolded protein response in expressing cells PMID: 29305604
- Results indicate a mechanism for beta-arrestin1 in the regulation of the prostate cancer procession through inhibiting FOXO3a. PMID: 29676828
- Studies indicate that the interaction of activated and phosphorylated GPCRs with the multifunctional adaptor proteins beta-arrestins (betaarrs) is crucial for regulation of their signaling and functional outcomes [Review]. PMID: 28651823
- The results show that PTEN controls multicellular assembly through a membrane-associated regulatory protein complex composed of beta-Arrestin1, ARHGAP21 and Cdc42. PMID: 28749339
- These results provide clear evidence that CXCR4- or CCR5-beta-arrestin complexes induce receptor endocytosis and signaling in the absence of G protein coupling and ligand-induced conformational changes of the receptor. PMID: 28733085
- Our results identify a new molecular mechanism involving miR-326 and Arrb1 as regulators of Sonic hedgehog medulloblastoma Cancer stem cells . Specifically, low levels of Arrb1 and miR-326 trigger and maintain Hh/Gli signaling and self-renewal PMID: 28716052
- This work demonstrates that the expression of FSHR and LHCGR can be induced in hGL5 cells but that the FSHR-dependent cAMP/PKA pathway is constitutively silenced, possibly to protect cells from FSHR-cAMP-PKA-induced apoptosis. PMID: 27502035
- Arrb1 reduced the chemotherapy-induced Lgr5 stem cell apoptosis by inhibiting endoplasmic reticulum stress-mediated mitochondrial apoptotic signaling. PMID: 27195676
- This study reveals contrasting abilities of IGF-1R to interact with each b-arrestin isoform, depending on the presence of the ligand and demonstrates the antagonism between the two b-arrestin isoforms in controlling IGF-1R expression and function, which could be developed into a practical anti-IGF-1R strategy for cancer therapy. PMID: 28581517
- Lowering the level of cellular FLNA caused an elevation in RalA activity and resulted in selective interference with the normal intracellular trafficking and signaling of D3R through beta-arrestins. PMID: 27188791
- findings suggest that knockdown of beta-arrestin 1 can suppress glioblastoma multiforme cell proliferation, invasion and glycolysis by inhibiting Src signaling PMID: 28442265
- the depleted beta-Arrestin1 reduced the interaction of P300 with Sp1, thus to reduce Sp1 binding to hTERT promoter, downregulate hTERT transcription, decrease telomerase activity, shorten telomere length, and promote Reh cell senescence. PMID: 28425985
- Data show that endothelin A receptor drives invadopodia function by direct interaction of beta-arrestin-1 (beta-arr1) with Rho guanine nucleotide exchange factor (GEF) 11 protein (PDZ-RhoGEF). PMID: 26522724
- The small GTPase Ras-related protein 2 (Rap2) was found to bind ArrB1 under resting conditions but dissociated upon formyl-Met-Leu-Phe stimulation. PMID: 27493245
- These results were consistent with those seen for beta2-AR. Thus, both beta-arrs negatively control AM1 receptor internalization, which depends on the C-tail of CLR. PMID: 28427767
- Results indicate a mechanism of beta-arrestin1 in modulating epithelial-mesenchymal transition (EMT) and glycogen synthase kinase 3 beta (GSK-3beta)/beta-catenin signaling in prostate cancer, and suggest that assessment of beta-arrestin1 may provide a potential therapeutic target for prostate cancer. PMID: 27620488
- The downregulation of beta-arrestins 1/2 in saphenous vein endothelial cells (SVECs) prevented the shear stress-induced rise in levels of phosphorylation of Akt and endothelial nitric oxide synthase (eNOS, Serine 1177). PMID: 28062183
- results suggest that ARRB1 plays an essential role in NK1R-mediated cell proliferation and G2/M transition in glioblastoma cells. Interference with ARRB1-mediated signaling via NK1R may have potential significance for therapeutic strategies targeting glioblastoma. PMID: 28341744
- The beta-arrestin1.STAM1 complex is necessary for promoting autophosphorylation of focal adhesion kinase (FAK). FAK is necessary for CXCL12-induced chemotaxis and associates with and localizes with beta-arrestin1 and STAM1 in a CXCL12-dependent manner. PMID: 27789711
- distinct ligands can leverage specific sequence elements on microR to regulate receptor endocytic lifetimes and the magnitude of arrestin-mediated signaling. PMID: 28153854
- CRIP1a can compete with beta-arrestins for interaction with C-terminal CB1R domains that could affect agonist-driven, beta-arrestin-mediated internalization of the CB1R. PMID: 27895162
- Low expression of ARRB1 is associated with lung cancer. PMID: 28035404
- In non-small cell lung cancer patients, the loss expression of beta-arrestin1 was frequently observed, and beta-arrestin1 expression was significantly correlated with the smoking index and E-cadherin expression, which all indicated beta-arrestin1's significant clinicopathologic role PMID: 26293896
- beta-arrestins regulate oxidative stress in a Nox4-dependent manner and increase fibrosis in heart failure. PMID: 26449263
- These results indicated that b-arr1 regulated ER stress/PUMA-induced mucosal epithelial apoptosis through suppression of the TNF-a/p65/iNOS signaling pathway activation and that b-arr1 is a potential therapeutic target for Portal hypertensive gastropathy. PMID: 26119788
- The nuclear accumulation of beta-arrestin 1 following TLR2 activation promote H4 acetylation at specific target gene promoters and may thus affect transcription of target genes in BM CD34+ cells. PMID: 26708616
- beta-arrestins functional involvement in myogenesis is presented. PMID: 26211463
- The identified receptor-phospho-selective mechanism for arrestin conformation and the spacing of the multiple phosphate-binding sites in the arrestin enable arrestin to recognize plethora phosphorylation states of numerous GPCRs. PMID: 26347956
- Data suggest that ARRB1 enhances hepatocellular carcinogenesis by inflammation-mediated Akt signaling. PMID: 26077142
- We conclude that beta-arrestin1 had a high expression in lung adenocarcinoma and beta-arrestin1 may be a promising biomarker to identify individuals with poor prognosis for patients with lung adenocarcinoma. PMID: 26097560
- Bradykinin stimulates pro-contractile signalling mechanisms in human myometrial cells and arrestin proteins play key roles in their regulation. PMID: 25766502
- After eight and 12 weeks of treatment with mirtazapine, scores on the 21-item Hamilton Depression Rating Scale (HAMD21) were significantly lower in patients with MDD with ARRB1 haplotype 1 than in those without haplotype 1 PMID: 25294870
- analysis of how NK1 receptor Gs versus Gq proteins and beta-arrestin signaling is determined by interactions in the water hydrogen bond network PMID: 26269596
- Multivariate analysis using the Cox regression model confirmed that co-expression of nuclear beta-arrestin1 and p65 was an independent prognostic factor for tumor progression (p = 0.008 PMID: 25820700
- Beta-arrestins regulate human cardiac fibroblast transformation in to a myofibroblast phenotype in ventricular remodeling. PMID: 25134464
- The potential role of ET-1/ETAR in promoting NF-kappaB signalling in EOC cells through beta-arr-1 recruitment, was examined. PMID: 24530737
- High ARBB1 expression is associated with metastasis in non-small cell lung cancers. PMID: 25401222
- A new role for Arr2 in the expression and activation of Androgen receptor and its potential relevance as a target for therapeutic intervention and monitoring of disease progression. PMID: 25109335
- Stimulation of multiple non-small cell lung cancer cell lines with nicotine led to enhanced recruitment of beta-arrestin-1 and E2F1 on vimentin PMID: 25600647
- IL6 stimulated SOD2 expression that, at least partially, contributed to the low level of ROS that would likely result in a sustained increase in the expression of IGF-1R through abolishment of beta-arrestin1 in docetaxel resistant cells. PMID: 24939178
- our findings reveal the existence of a novel mechanism by which ETAR/beta-arr1 signaling is integrated with the Wnt/beta-catenin pathway to sustain chemoresistance in epithelial ovarian cancer, and they offer a solid rationale for clinical evaluation PMID: 25377471
- TSH stimulated translocation of beta-arrestin-1 to TSHR. beta-arrestin-1 downregulation inhibited TSH-stimulated phosphorylation of ERK1/2, p38alpha, and AKT1. Activatory signals mediated by beta-arrestin-1 cause TSH-enhanced osteoblast differentiation in U2OS cells. PMID: 24723693
- the primary function of betaARRs and ECE-1 in SP-dependent inflammatory signaling is to promote resensitization, which allows the sustained NK1R signaling from the plasma membrane that drives inflammation PMID: 24898255
- A novel function of beta-arrestin1 binding to EZH2 to promote chronic myeloid leukemia progression by regulating BCR/ABL-histone H4 acetylation. PMID: 24937675
- Nuclear ARRB1 induces pseudohypoxia and cellular metabolism reprogramming in prostate cancer. PMID: 24837709
- The transient up-regulation of miR-525-3p, and the resultant repression of its direct targets ARRB1, TXN1 and HSPA9, is required for cell survival following irradiation. PMID: 24147004
顯示更多
收起更多
-
亞細(xì)胞定位:Cytoplasm. Nucleus. Cell membrane. Membrane, clathrin-coated pit. Cell projection, pseudopodium. Cytoplasmic vesicle.
-
蛋白家族:Arrestin family
-
數(shù)據(jù)庫鏈接:
Most popular with customers
-
-
YWHAB Recombinant Monoclonal Antibody
Applications: ELISA, WB, IHC, IF, FC
Species Reactivity: Human, Mouse, Rat
-
Phospho-YAP1 (S127) Recombinant Monoclonal Antibody
Applications: ELISA, WB, IHC
Species Reactivity: Human
-
-
-
-
-